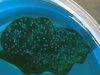

festaedan
potamotrygon fan
Hey guys
Right after basketball practice I went to check on my new angels and I found some eggs! I was surprised to see that they didnt spawn on the filter intake.
These angels actually survived a pretty bad car accident on their way home so maybe the extra stress plus new water triggered it.
Either way, they spawned and I'm happy about it.
I have bred a plethora (hope Im using that right ) of Ca/Sa cichlids but never angels so i have a few questions.
) of Ca/Sa cichlids but never angels so i have a few questions.
As of now they are guarding the babies well, but should I pull them? There are 7 other angels, 5 bn plecos, and a pair of kribs in the tank.
Come to think about it, thats my only question.
Here are some pictures and a video of the parents and eggs:



The video below might be still uploading depending on how early you see this. If it is, check back later. I think I did a good job with it
[YT]xwijFzjylpc&feature[/YT]
Thanks!



Right after basketball practice I went to check on my new angels and I found some eggs! I was surprised to see that they didnt spawn on the filter intake.
These angels actually survived a pretty bad car accident on their way home so maybe the extra stress plus new water triggered it.
Either way, they spawned and I'm happy about it.
I have bred a plethora (hope Im using that right
As of now they are guarding the babies well, but should I pull them? There are 7 other angels, 5 bn plecos, and a pair of kribs in the tank.
Come to think about it, thats my only question.
Here are some pictures and a video of the parents and eggs:



The video below might be still uploading depending on how early you see this. If it is, check back later. I think I did a good job with it
[YT]xwijFzjylpc&feature[/YT]
Thanks!